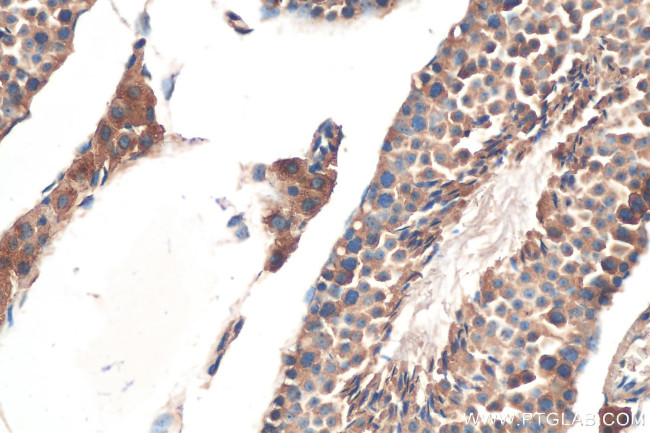
Kallikrein 5 Antibody in Immunohistochemistry (Paraffin) (IHC (P))

Search
Proteintech
Kallikrein 5 Polyclonal Antibody
{{$productOrderCtrl.translations['antibody.pdp.commerceCard.promotion.promotions']}}
{{$productOrderCtrl.translations['antibody.pdp.commerceCard.promotion.viewpromo']}}
{{$productOrderCtrl.translations['antibody.pdp.commerceCard.promotion.promocode']}}: {{promo.promoCode}} {{promo.promoTitle}} {{promo.promoDescription}}. {{$productOrderCtrl.translations['antibody.pdp.commerceCard.promotion.learnmore']}}
产品信息
10514-2-AP
种属反应
已发表种属
宿主/亚型
分类
类型
抗原
偶联物
形式
浓度
纯化类型
保存液
内含物
保存条件
运输条件
产品详细信息
Immunogen sequence: DCDMHTQPW QAALLLRPNQ LYCGAVLVHP QWLLTAAHCR KKVFRVRLGH YSLSPVYESG QQMFQGVKSI PHPGYSHPGH SNDLMLIKLN RRIRPTKDVR PINVSSHCPS AGTKCLVSGW GTTKSPQVHF PKVLQCLNIS VLSQKRCEDA YPRQIDDTMF CAGDKAGRDS CQGDSGGPVV CNGSLQGLVS WGDYPCARPN RPGVYTNLCK (72-280 aa encoded by BC008036)
靶标信息
Kallikreins are a subgroup of serine proteases and are implicated in carcinogenesis. A novel KLK gene, KLK12, is expressed in a variety of tissues including salivary gland, stomach, uterus, lung, thymus, prostate, colon, brain, thyroid, and trachea. It has applications as a novel cancer biomarker.
仅用于科研。不用于诊断过程。未经明确授权不得转售。
生物信息学
蛋白别名: HK5; kallikrein 5; Kallikrein L2; Kallikrein like 2; Kallikrein-5; Kallikrein-like protein 2; kallikrein-related peptidase 5; Kallikrein5; KLK 5; KLK L2; KLK-5; KLK-L2; KLKL 2; Stratum corneum tryptic enzyme
基因别名: KLK-L2; KLK5; KLKL2; SCTE; UNQ570/PRO1132
UniProt ID: (Human) Q9Y337
Entrez Gene ID: (Human) 25818